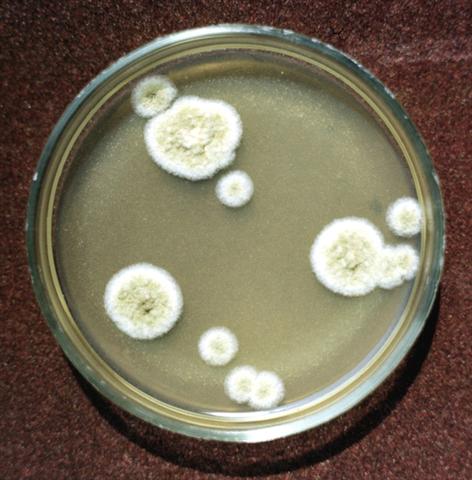
Колонии грибка Aspergillus flavus на среде Сабуро

Колонии грибка Aspergillus flavus на среде Сабуро

|
Рис. 3. Колонии грибка Aspergillus flavus на среде Сабуро (пятидневная культура). |
Перейти к статье «Аспергиллёз»
|
Рис. 3. Колонии грибка Aspergillus flavus на среде Сабуро (пятидневная культура). |